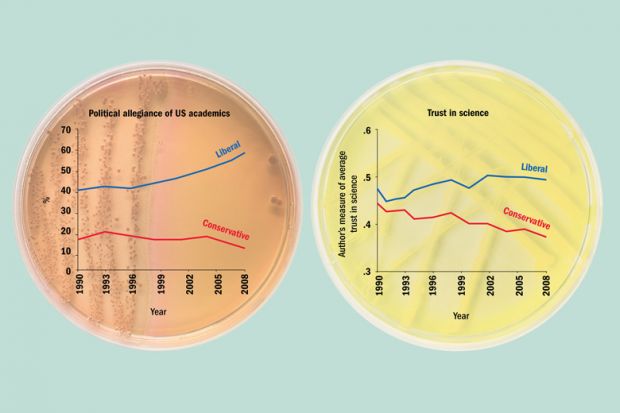

View or download a high-resolution version
Last week, echoing other commentators, Jeremy Berg, the new editor-in-chief of the journal Science, told Times Higher Education that there was a “crisis in public trust in science” and that scientists were now seen as just another interest group.
Meanwhile, there has been a flurry of discussion in the US asking whether universities are hostile environments for conservatives, especially in the wake of the release in March of Passing on the Right: Conservative Professors in the Progressive University, a book that found that conservative academics often hide their allegiances until gaining tenure.
Left graph: data are from surveys of college faculty conducted by the Higher Education Research Institute every other year and compiled by Heterodox Academy, which campaigns for ideological diversity in universities. “Liberal” includes those identifying as “far left”, and “conservative” includes “far right”. Moderates have been excluded.
Right graph: taken from “Politicization of Science in the Public Sphere: A Study of Public Trust in the United States”, published in the American Sociological Review in 2012. Moderates have been excluded.
POSTSCRIPT:
Print headline: Suspicious minds: US conservatives’ distrust of science
Register to continue
Why register?
- Registration is free and only takes a moment
- Once registered, you can read 3 articles a month
- Sign up for our newsletter
Subscribe
Or subscribe for unlimited access to:
- Unlimited access to news, views, insights & reviews
- Digital editions
- Digital access to THE’s university and college rankings analysis
Already registered or a current subscriber?